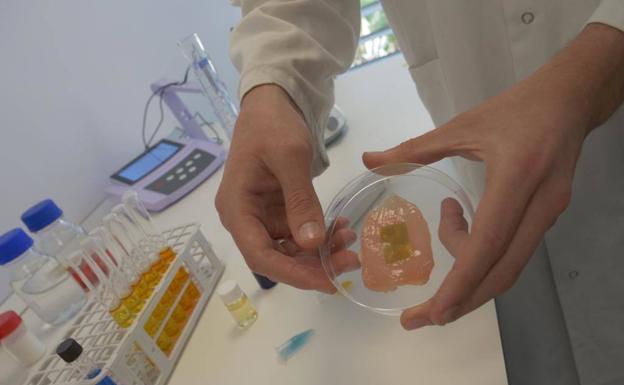
Una start-up ilicitana, entre las 20 mejores empresas de tecnología alimentaria

Retener y recuperar talento: dos objetivos del Parque Científico de la UMH
Susana Almenar | Alicante
El Pcumh celebra su 15º aniversario y hasta ahora ha generado 300 puestos de trabajo de alta cualificación | Ha impulsado 160 empresas con sus programas de emprendimiento